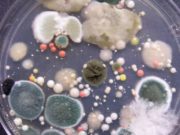
Me këto sëmundje ballafaqohen familjet të cilat nuk i zbathin këpucët në shtëpi

Me këto sëmundje ballafaqohen familjet të cilat nuk i zbathin këpucët në shtëpi
Është traditë e myslimanëve (falë Zotit, edhe e shqiptarëve) që të heqin këpucët kur hyjnë në shtëpi.
Por në shumë kultura, e posaqërisht në kulturën...
Allahu i pranon veprat e mira vetëm nga të sinqertët
Transmetohet se një sundimtar musliman deshi të ndërtonte një xhami në qytetin e tij dhe urdhëroi që askush të mos merrte pjesë në ndërtimin...
Eja në Islam, jeto lart!
Kjo rrugë është e hapur vetëm për ata që DUAN! Jashtë këtij kushti, ajo mbetet thjeshtë një copë toke, dritën e së cilës s’mund...
A janë muslimanët majft të arsimuar?
Në bazë të studimeve, edhe pse numerikisht ndër më të paktët në botë, hebrenjtë kanë më shumë vite të arsimimit formal nga të gjitha...
DYNJAJA ËSHTË KALIMTARE!
Ibn Omeri, Allahu qoftë i kënaqur me të!, ka thënë: I dërguari i Allahut vendosi dorën e tij mbi supin (krahun tim) tim dhe...
Mrekullia e Allahut në krijimin e devesë
Deveja njihet nga të gjithë si kafsha që i reziston gjatë etjes, por përveç kësaj çfarë e bën devenë kaq të mrekullueshme?
Allahu i Madhëruar...
MEDITIME KURANORE
1. Allahu, xhele ue ala, ka thënë; “O ju besimtarë, pëmbajuni mësimeve të All-llahut dhe thuani fjalë të drejta.” (El Ahzab; 70).
Me të vërtetë...
ÇASTI PAS NAMAZIT TË IKINDISË, ÇAST KUR PRANOHEN LUTJET
Neglizhenca ndaj përfitimit të mirësive dhe begative në këtë çast.
Ibn Kajimi, Allahu e mëshiroftën thotë:
“Ky çast është koha e fundit pas namazit të...